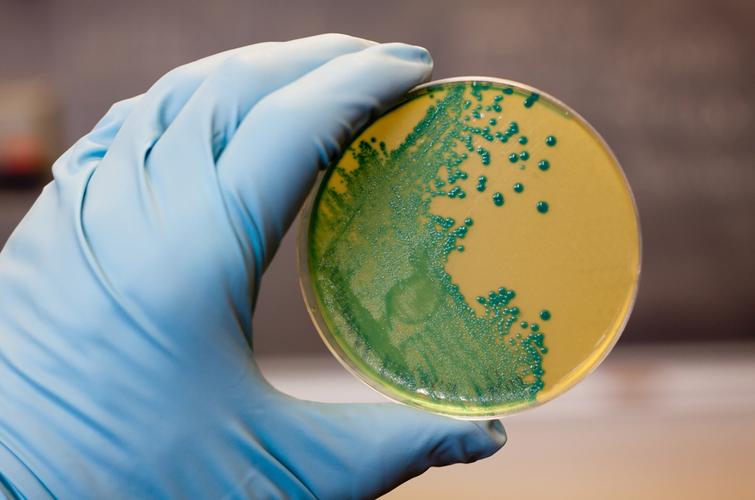
Cтійкі до ліків бактерії можуть поширюватися від людей до диких тварин

Cтійкі до ліків бактерії можуть поширюватися від людей до диких тварин
Фото: DepositphotosГрупа дослідників з низки наукових установ, включаючи університет Хоккайдо в Японії, в ході свого дослідження виявили, що стійкі до ліків бактерії можуть поширюватися від людей у водне середовище, а також до диких тварин.
Про це повідомляє NHK.
Зазначається, що стійкі до антибіотиків бактерії стали серйозною проблемою в Японії та за кордоном.
Вважається, що такі бактерії все більше поширюються через надмірне або неправильне використання антибіотиків, зокрема, коли пацієнти припиняють приймати ліки, поки мікроби залишаються в їхньому організмі.
У центрі уваги дослідницької групи був клон ST131 бактерії E.coli, що має високий рівень стійкості до антибіотиків.
Група виділила ST131 із проб озерної та річкової води, а також з фекалій диких тварин, включаючи єнотоподібних собак та оленів, взятих у префектурах Гіфу та Сіга протягом шести років по 2021 рік, та проаналізувала генетичні особливості.
Аналіз показав близьку генетичну схожість ST131 між людьми, водним середовищем та дикими тваринами, що говорить про можливе поширення бактерії від людей у природу.
Дослідники попереджають, що якщо не вжити жодних заходів, то стійкі до ліків бактерії можуть ще більше поширитися у природі, а потім перейти від тварин назад до людей, викликаючи спалахи нових інфекційних захворювань.